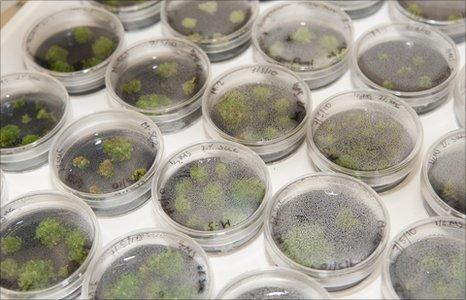
Anagramma fern growing in culture

The tiny fern was clinging to a precarious existence on a mountain ridge
In a small, noisy laboratory, tucked away in London's Royal Botanic Gardens at Kew, a tiny plant is growing.
It looks just like a very small parsley bush, but it is actually a very special little plant indeed.
Clean air has to be constantly circulated in the lab to protect it from any bacteria.
This precious specimen is the Anogramma ascensionis fern, commonly known as the parsley fern. Since the 1950s, botanists believed it to be extinct.
It is native to Ascension - an island in the South Atlantic, which is one of Britain's overseas territories. And a small project supported by Kew's overseas territories programme has rediscovered and rescued it - a timely success story, as this year has been dubbed International Year of Biodiversity.
Kew botanist Phil Lamden and local conservation officer Stedson Stroud found the plucky little plant clinging to a precarious existence on a mountainside in the harsh volcanic landscape.
"We were down the back of Ascension's Green Mountain, which has very, very steep slopes. You have to be really careful because if you slip you're a goner," Mr Stroud recalled.
"And we came across this beautiful little fern and immediately knew it was the lost Anogramma that had been extinct for the last 60 years."
Ascension is covered by bleak, forbidding lava flows, and only 10 plant species are known to be truly "endemic" - found nowhere else in the world.

Stedson Stroud (left) scrambled down the mountain to tend the plants
According to Kew scientists, goats that were released on to Ascension by Portuguese explorers in the 1500s, ate their way voraciously through the island's greenery for 350 years before any of the flora was even described to science.
The introduction of more invasive herbivores - rabbits, sheep, rats and donkeys, together with over 200 species of invasive plants, further squeezed out the island's original plant inhabitants. The rediscovery of Anogramma boosts to seven the number of surviving endemic plant species on the island.
Mr Stroud said that, in the excitement, both of the researchers "forgot where they were".
"We were scrambling around, looking to see if there were more, and then we realised, we should really have safety ropes and stuff around us," he said.
24-hour rescue
There were more plants - four in total. But as far as the researchers knew, these were all that remained of Anogramma. So with the help of his colleague, Olivia Renshaw, Mr Stroud mounted a rather perilous effort to protect them.

The tiny fern plants had to be drip-fed
"We had to keep the plants alive - they were on a bare rock face and it was a really dry period, so Olivia and I went down twice a week carrying water and we set up a drip feed," said Stedson.
After a few weeks of tending the plants, the next part of their plan was even more risky. They had to get pieces of the ferns back to Kew so that more plants could be grown in the safety and sterility of the lab.
Stedson climbed down the ridge one again - this time to collect a few small cuttings of the spore-forming or reproductive parts of the plants.
Once harvested, the spores were vulnerable to drying and contamination, and the team had just 24 hours to transfer the precious cargo to the laboratory in Kew's Conservation Biotechnology Unit (CBU).

Ascension island is a forbidding, volcanic landscape
The samples were placed in a sterile container and rushed to the nearby airfield. From there, they were flown to a military airport in the UK, where a car was waiting to race them to Kew. Fortunately, the dust-like fern spores survived the journey intact.
Dr Viswambharan Sarasan is head of the CBU. He explained that their arrival was not the end of the challenge.
The spores had to be bleached to eliminate any bacteria, before the plants could be grown in culture.
"That is the really risky part," he said. "If you bleach them for too long, you could kill the spores, but if you don't treat them for long enough, there could be remaining bacteria that will grow in culture and kill them."
And Dr Sarasan had only a 1p-piece-sized clipping of fern to work with - the smallest sample he had ever cultured from.
After another nervous period of waiting, he was relieved to discover that the process had left the spores intact and viable.
He and his colleague Katie Baker, a botany undergraduate student working at Kew, have now succeeded in growing 60 new Anogramma plants in culture - all from four tiny plants on a cliff face in Ascension.
The team hope eventually to restore Anogramma to its former wild habitats on Ascension's Green Mountain.
And Mr Stroud has even managed to grow some of the plants in a shade house on the island itself.
"Each and every day, you're there, tending and looking, and hoping that something will happen," he said.
"Then one day you see something and - watching the plants grow - you can't ask for anything more."
Kew scientists have successfully grown more than 60 Anogramma plants
Colin Clubbe, who leads the UK overseas territories programme at Kew, says that this rescue effort was a small but vital part of a much wider goal to protect native plants in Britain's overseas territories before they are lost forever.
Plants are such an important component of our lives," he said. "And if we lose them, we lose them - extinction is forever.
He says that "holding on to our natural environment" could help us protect many of the plants we depend on.
"We do exploit species - we're reliant on plant products. We use them as a source of genes and, in these extremely dry habitats, like Ascension, plants that are naturally adapted may hold some answers to things like plants' responses to climate change."
This is actually the third extinct plant that Mr Stroud has rediscovered and, for him, it is an ongoing and very personal mission.
"There's never a time that I'm not actually looking fort these species because, we say they're extinct, but I believe they are there," he said.
"It's so satisfying, bringing a plant back from the brink of extinction."
Hear more from the researchers on Science in Action on the BBC World Service on Friday 25 June.
- Published19 May 2010